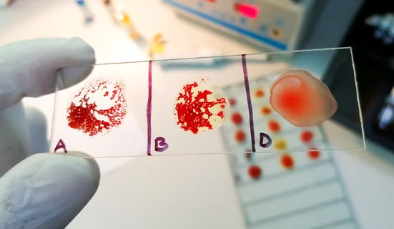

O형 혈액이 모두에게 수혈 가능한 이유
- 카테고리 없음
- 2025. 2. 2. 03:35
O형 혈액이 모두에게 수혈 가능한 이유
O형 혈액은 헌혈 및 응급 수혈 시 가장 유용한 혈액형으로 알려져 있다. 특히 O형 Rh(-) 혈액은 응급 상황에서 모든 혈액형에게 수혈할 수 있어 "범용 공혈자(universal donor)"라고 불린다. 그렇다면 왜 O형 혈액이 모든 혈액형에게 수혈이 가능한지? 이번 글에서 O형 혈액의 특징, 항원·항체 반응, 수혈 원칙 및 주의사항까지 5개 항목으로 상세히 정리해보겠다.
1. 혈액형이 결정되는 원리 (ABO식 혈액형 분류)



✅ (1) ABO식 혈액형의 특징
사람의 혈액형은 적혈구 표면에 존재하는 항원(A, B)과 혈장 내 항체(항A, 항B)의 조합에 따라 결정된다.
혈액형 적혈구 표면의 항원 혈장 내 항체
| A형 | A 항원 | 항B 항체 |
| B형 | B 항원 | 항A 항체 |
| AB형 | A 항원 + B 항원 | 없음 |
| O형 | 없음 | 항A 항체 + 항B 항체 |
📌 즉, O형 혈액은 적혈구 표면에 A, B 항원이 없기 때문에, 어떤 혈액형에게 수혈해도 항원-항체 반응이 발생하지 않는다.
✅ (2) 혈액형과 수혈 반응
✔ 혈액을 수혈할 때는 항원(A, B)과 항체(항A, 항B)의 반응이 중요
✔ 잘못된 혈액형을 수혈하면 항체가 이질적인 항원을 공격하여 응집(혈액응고) 반응이 일어남 → 혈전 생성, 생명 위협
📌 즉, O형은 A, B 항원이 없으므로 모든 혈액형에게 안전하게 수혈할 수 있다.
2. O형 혈액이 모두에게 수혈 가능한 이유 (범용 공혈자)



✅ (1) O형 혈액은 적혈구 표면에 A/B 항원이 없음
✔ A, B, AB형 혈액은 각각 항원이 있지만, O형은 항원이 없어서 면역 반응이 일어나지 않음
✔ 따라서 O형 적혈구를 포함한 혈액을 모든 혈액형에게 안전하게 수혈 가능
✅ (2) 혈장 내 항체는 제거 후 수혈
✔ O형 혈장은 항A·항B 항체를 포함하고 있어 직접 수혈하면 항원-항체 반응이 일어날 수 있음
✔ 수혈할 때는 적혈구 성분만 사용(적혈구제제)하여 혈장 항체를 제거 후 수혈
✅ (3) O형 Rh(-) 혈액은 "완전한 범용 공혈자"
✔ Rh(-)는 Rh 항원이 없으므로, Rh(+) 혈액형에게도 수혈 가능
✔ O형 Rh(-) 혈액은 어떤 혈액형에게도 100% 안전하게 수혈 가능 → 응급 상황에서 가장 중요한 혈액
📌 즉, O형 혈액은 항원이 없어 모든 혈액형에게 안전하게 적혈구 수혈이 가능하며, Rh(-) O형은 완벽한 범용 공혈자로 활용된다.
3. 수혈 원칙과 제한 사항 (O형도 모든 경우 수혈 가능한가?)



✅ (1) 적혈구 수혈과 혈장 수혈의 차이
✔ 적혈구 수혈(범용 공혈자) – O형은 모든 혈액형에게 수혈 가능
✔ 혈장 수혈(범용 수혈자: AB형) – O형 혈장은 항A·항B 항체를 포함하므로 모든 혈액형에게 수혈하면 안 됨
✔ 따라서 O형은 적혈구만 수혈하는 것이 원칙
✅ (2) 응급 상황에서 O형 사용 원칙
✔ 병원에서 혈액형 검사가 어려운 응급 상황에서는 O형 Rh(-) 혈액을 우선적으로 사용
✔ 일반적인 경우 혈액형을 정확히 검사한 후 동일한 혈액형을 수혈하는 것이 원칙
✅ (3) 수혈 후 면역 반응 발생 가능성
✔ 반복적으로 O형 혈액을 타 혈액형에게 수혈하면 미세한 면역 반응 발생 가능성 있음
✔ 장기적인 경우 혈액형이 일치하는 혈액을 수혈하는 것이 바람직함
📌 즉, O형은 적혈구 수혈 시 모든 혈액형에게 사용 가능하지만, 혈장 수혈은 제한되며, 장기적으로는 혈액형 일치를 원칙으로 한다.
4. Rh(-) O형 혈액이 가장 중요한 이유 (응급 수혈 필수 혈액)

✅ (1) Rh(-) 혈액이 희귀한 이유
✔ 한국인의 Rh(-) 혈액 비율은 0.3~0.5%로 매우 희귀
✔ O형 Rh(-)는 가장 찾기 어려운 혈액 중 하나
✅ (2) Rh(-) O형이 모든 Rh(+)에게도 수혈 가능한 이유
✔ Rh 항원이 없어 Rh(+) 혈액형에게도 면역 반응 없이 수혈 가능
✔ 응급 상황에서 혈액형 검사가 어려울 때 최우선으로 사용
✅ (3) 응급 헌혈 및 비축의 중요성
✔ Rh(-) 혈액은 수혈 대상이 적어 비축 혈액이 부족한 경우가 많음
✔ 특히 O형 Rh(-) 혈액은 수혈 필요성이 높아 정기적인 헌혈이 필수적
📌 즉, Rh(-) O형 혈액은 가장 희귀하면서도 응급 수혈에서 가장 중요한 혈액이다.
5. O형 혈액 관련 궁금한 점 (Q&A)



❓ Q1. O형이면 누구에게나 수혈해도 정말 괜찮은가?
🚗 적혈구 수혈은 가능하지만, 혈장은 수혈하면 안 됨
🚗 O형 혈장은 항A·항B 항체가 있어 다른 혈액형에게 수혈 시 면역 반응 발생 가능
❓ Q2. O형 Rh(-) 혈액이 없을 때 Rh(+)를 수혈할 수 있나?
🚗 Rh(-) 혈액이 없으면 긴급한 경우 O형 Rh(+) 혈액을 사용할 수도 있음
🚗 하지만 Rh(-) 환자에게 Rh(+) 혈액을 반복 수혈하면 면역 반응 발생 가능
❓ Q3. 왜 응급 상황에서 O형 Rh(-) 혈액을 사용하나?
🚗 혈액형 검사가 불가능한 긴급 상황에서는 모든 혈액형에게 안전하게 수혈 가능하기 때문
❓ Q4. O형인 사람이 O형만 수혈받을 수 있는 이유는?
🚗 O형은 혈장 내 항A·항B 항체를 가지고 있어, A형, B형, AB형의 적혈구를 수혈하면 면역 반응 발생
🚗 따라서 O형은 O형 혈액만 수혈 가능
📌 즉, O형은 수혈할 때는 "범용 공혈자"이지만, 수혈받을 때는 "제한적 수혈자"가 된다.
📌 결론
✔ O형 혈액은 적혈구 표면에 A/B 항원이 없어 모든 혈액형에게 수혈 가능
✔ O형 Rh(-) 혈액은 완전한 범용 공혈자로 응급 수혈에서 가장 중요한 혈액
✔ O형 혈장은 항A·항B 항체가 있어 수혈하면 안 됨
✔ 응급 상황에서는 혈액형 검사가 어려워 O형 Rh(-) 혈액이 최우선적으로 사용됨
✔ O형 환자는 O형 혈액만 수혈 가능하므로, 장기적으로는 혈액형이 맞는 수혈이 원칙
📌 O형 혈액은 수혈할 때는 가장 유용하지만, 반대로 수혈받을 때는 제한적이므로 헌혈이 중요하다!